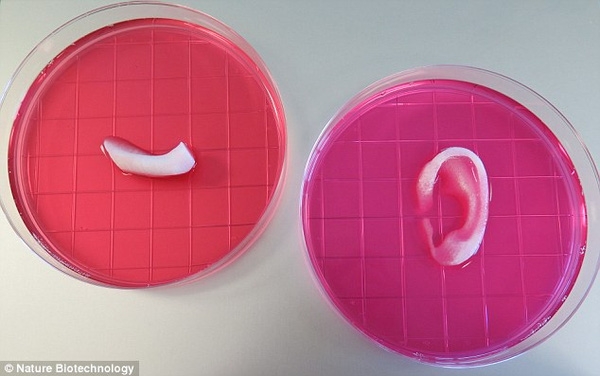

Theo báo cáo được công bố trên tạp chí Nature Biotechnology, thành tựu mang tính đột phá này được thực hiện bởi các nhà khoa học ngành Y học tái tạo thuộc Trung Tâm Y tế Wake Forest Baptist (WFBMC) có trụ sở tại Winston-Salem (Mỹ). Loại máy in 3D mà họ sử dụng thuộc loại 3D sinh học (3D bio-printer).

Đã có thể in tai người "còn sống".
“Trước đây, người ta đã sử dụng máy in 3D sinh học để in tế bào theo từng lớp, tạo thành mô hoặc các cơ quan trong cơ thể. Tuy nhiên, thành phẩm in ra vẫn chưa thể ghép lên cơ thể người do thiếu tính ổn định, các mô quá nhỏ (khoảng 200 micromet, khó hoạt động trên cơ thể) và đặc biệt là không thể in mạch máu”, Tiến sĩ Anthony Atala – người đứng đầu nhóm nghiên cứu – mở đầu bài phát biểu.
Theo Tiến sĩ Anthony, nhóm đã nghiên cứu và đưa ra giải pháp cho vấn đề này, bằng cách thêm vào đó một dạng polymer sinh học. Lúc này, các tế bào tạo thành có kết cấu khỏe hơn rất nhiều, từ đó đủ sức chịu đựng cho đến khi hình thành mô mới.


Cận cảnh máy in chiếc tai.
“Chúng tôi đã tính đến thời gian tế bào sống để kết nối với cơ thể, điều đó quả thực nan giải. Từ đây, nhóm đã ứng dụng Hệ thống tích hợp mô và nội tạng (Itop) từng được xây dựng trong 10 năm để chế tạo thành công ‘mực sinh học’ với thành phần chính là nước. Loại ‘mực’ này sẽ làm nhiệm vụ kết nối tế bào với nhau cũng như tạo hệ thống ống dẫn siêu nhỏ nhằm vận chuyển ô-xi và chất dinh dưỡng nuôi bộ phận đó phát triển thành mô”, Tiến sĩ Anthony giải thích.

Tiến sĩ Anthony.
Nhóm sau đó tiếp tục chứng minh cho nghiên cứu của mình bằng thí nghiệm trên chuột. Bằng cách cấy chiếc tai 3D dưới da động vật này, khoảng 2 tháng sau, chiếc tai vẫn nguyên vẹn và đã hình thành nhiều mô sụn cũng như các mạch máu.
Theo các chuyên gia y học, thành tựu của WFBMC được xem là đột phá ở thời điểm hiện tại. Dù chưa thử nghiệm trên người nhưng trong tương lai, điều đó hoàn toàn sẽ có thể xảy ra.

Cận cảnh chiếc tai.
“Đây là bước đột phá cả công nghệ in 3D lẫn y học. Trong tương lai, chúng ta sẽ không cần phải nhờ đến hiến tạng mà đã có thể ‘sản xuất’ ra các bộ phận để cấy ghép. Tất nhiên, giá cả cũng không còn đắt đỏ như hiện tại”, một nhà khoa học nhận định.
Theo Yan
Mời bạn xem thêm:
Chàng trai chế tạo robot in 3D trẻ nhất thế giới
Cách làm máy chiếu hologram lập thể 3D từ thật dễ dàng
Cỗ máy xây nhà bằng công nghệ in 3D lớn nhất thế giới
